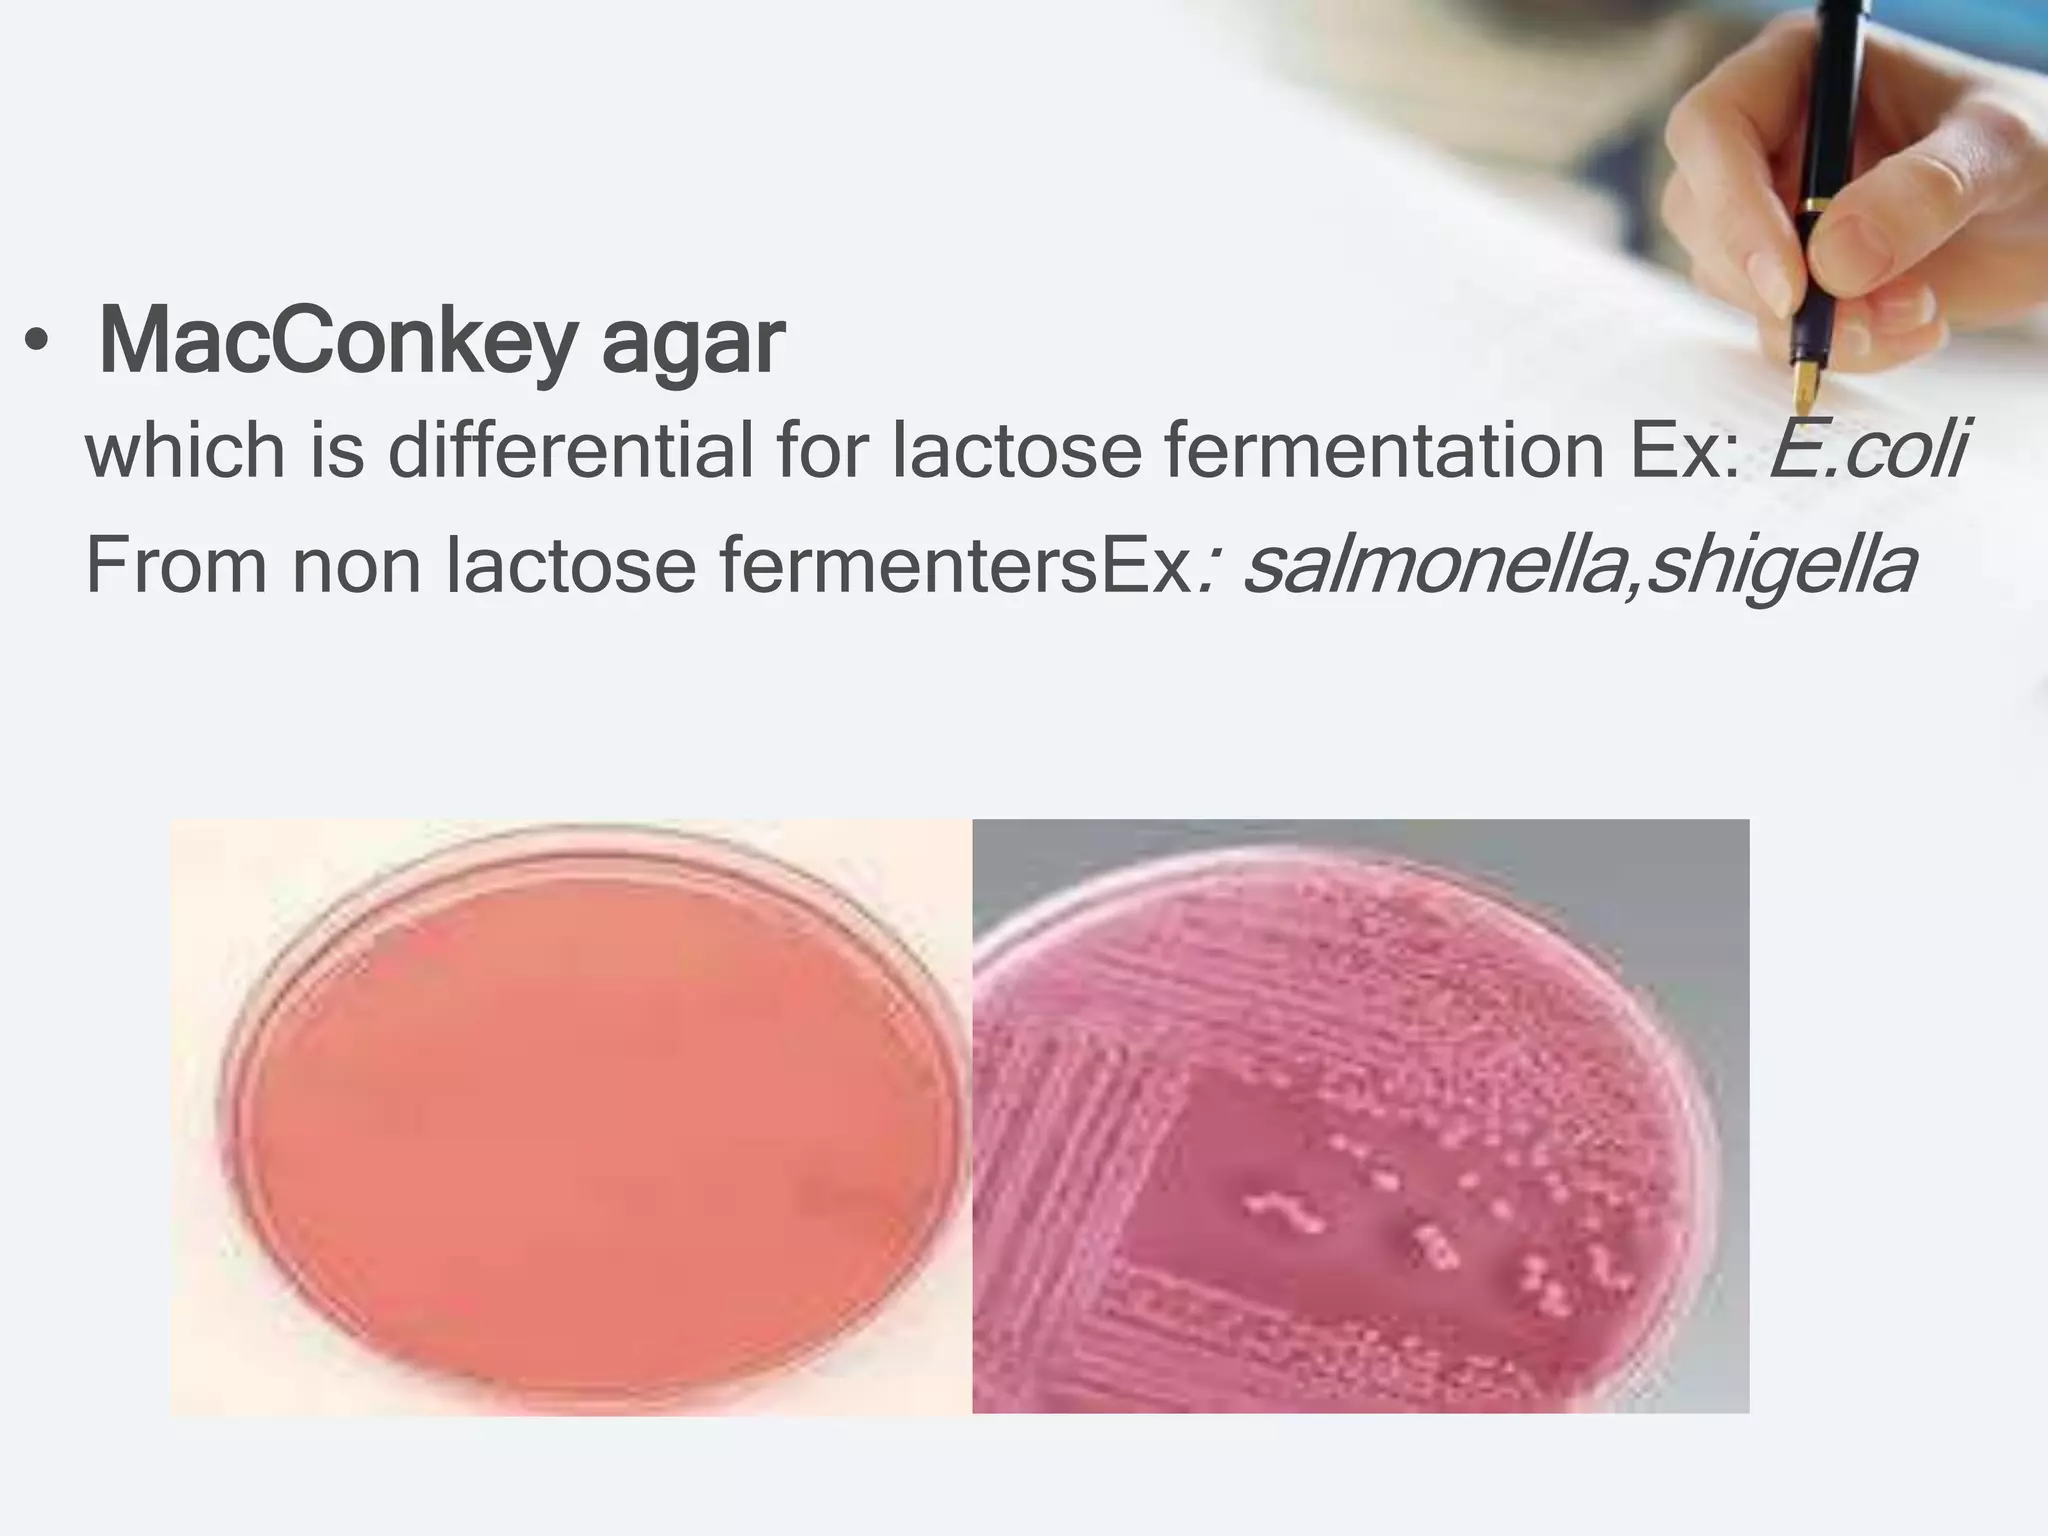
• MacConkey agar
which is differential for lactose fermentation Ex: E.coli
From non lactose fermentersEx: salmonella,shigella
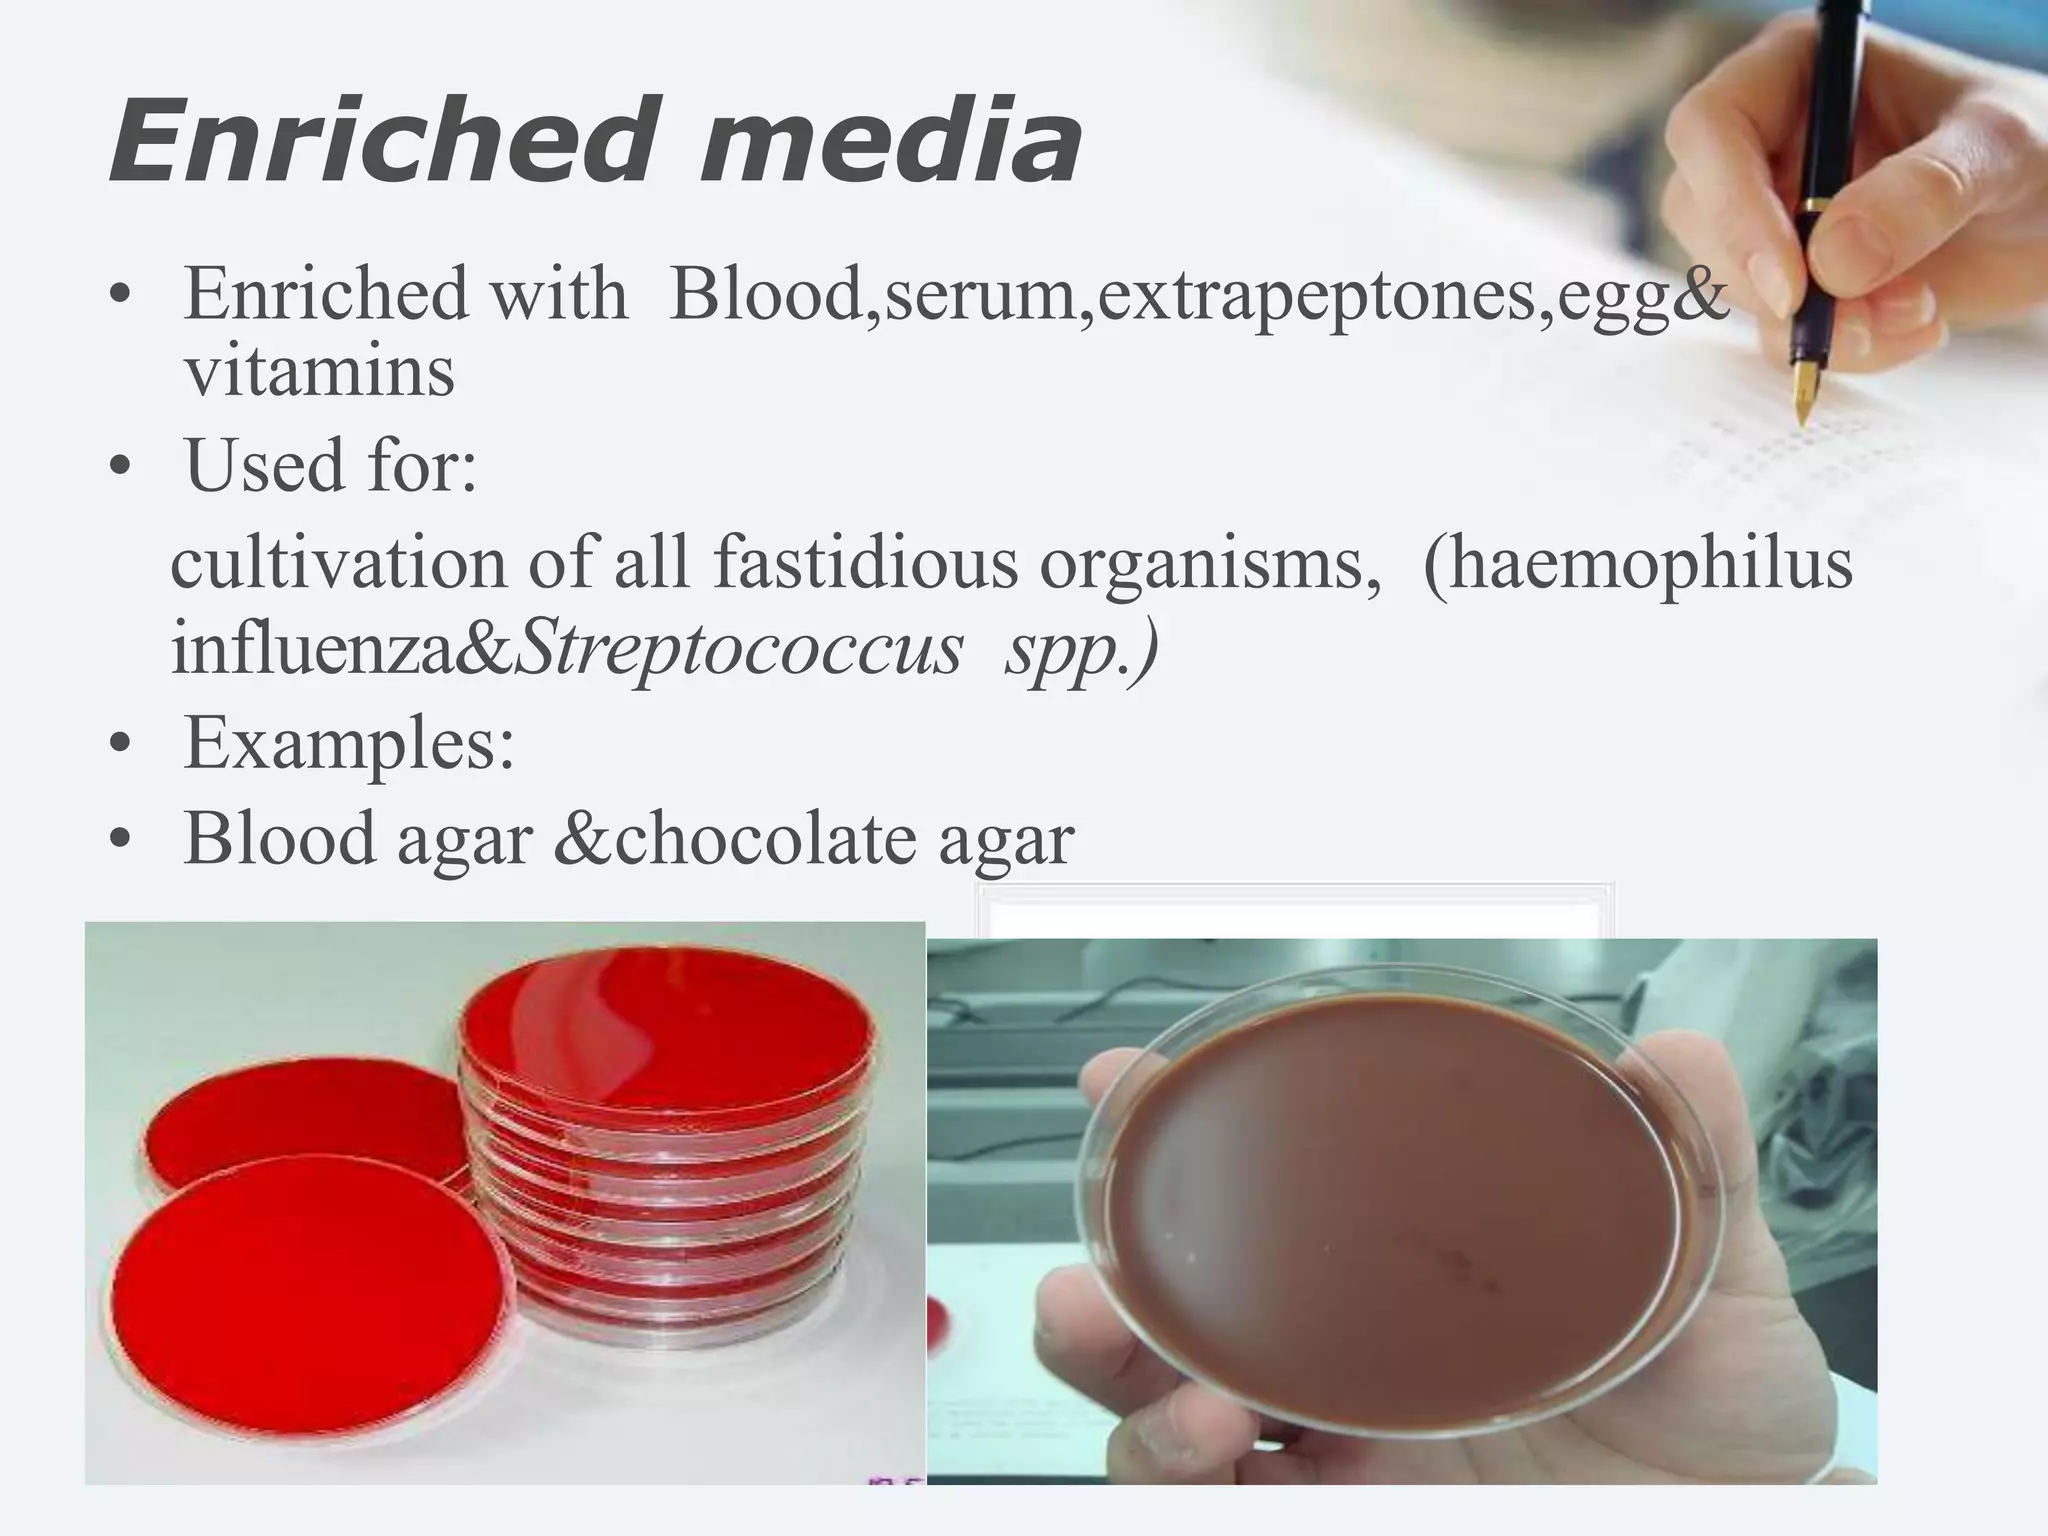
Enriched media
• Enriched with Blood,serum,extrapeptones,egg&
vitamins
• Used for:
cultivation of all fastidious organisms, (haemophilus
influenza&Streptococcus spp.)
• Examples:
• Blood agar &chocolate agar

The document outlines the nutritional requirements, preparation, classification, and physical parameters for culture media used in cultivating microorganisms. It details various types of media, including basic, selective, differential, enriched, and transport media, highlighting their components and specific uses in microbiology. Key components for growth are also addressed, including chemical and physical requirements such as nutrients and environmental conditions.